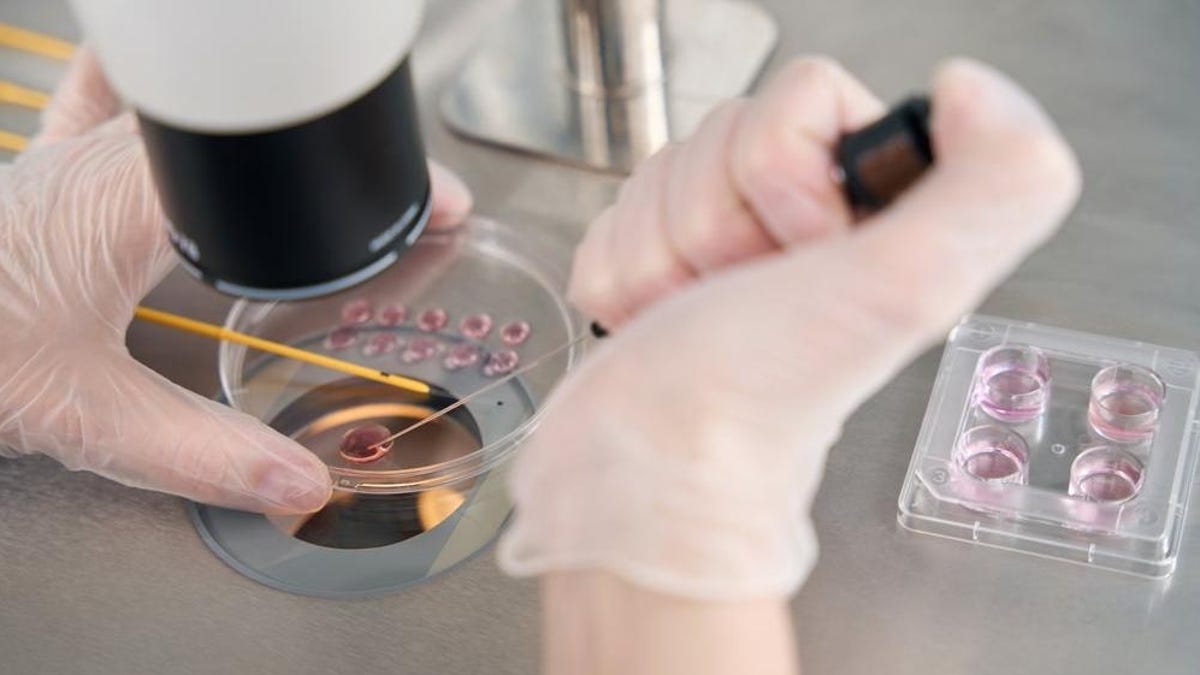
Επιστήμονες συνθέτουν για πρώτη φορά έμβρυα που μοιάζουν με τον άνθρωπο

Επιστήμονες συνθέτουν για πρώτη φορά έμβρυα που μοιάζουν με τον άνθρωπο
Επιστήμονες στο Ηνωμένο Βασίλειο και τις Ηνωμένες Πολιτείες δημιούργησαν
συνθετικό που μοιάζει με άνθρωπο
έμβρυα
χωρίς να χρειάζονται ωάρια ή σπέρμα
. Αν και το έμβρυο δεν έχει εγκέφαλο ή καρδιακό παλμό, οι επιστήμονες ελπίζουν ότι θα ρίξει φως στην αιτία των αποβολών και
γενετικές ασθένειες
.
Η ερευνητική ομάδα χρησιμοποιεί τα συνθετικά έμβρυα, εν μέρει, για να ανακαλύψει γιατί ορισμένες εγκυμοσύνες δεν συνεχίζονται μετά τις πρώτες 14 ημέρες της γονιμοποίησης. «Γνωρίζουμε πολύ λίγα για αυτό το βήμα στην ανθρώπινη ανάπτυξη, αλλά είναι μια εποχή που χάνονται πολλές εγκυμοσύνες, ειδικά σε περιβάλλον εξωσωματικής γονιμοποίησης», είπε ο Roger Sturmey, ανώτερος ερευνητής για την υγεία της μητέρας και του εμβρύου στο Πανεπιστήμιο του Μάντσεστερ στο Ηνωμένο Βασίλειο. CNN.
Το πρόβλημα εξακολουθεί να υπάρχει ότι αυτά τα συνθετικά έμβρυα διαφέρουν από ένα έμβρυο που έχει συλληφθεί με φυσικό τρόπο, το οποίο οι επιστήμονες προσπαθούν να μελετήσουν διατηρώντας τα «έμβρυα εξωσωματικής γονιμοποίησης ζωντανά σε ένα πιάτο για 14 ημέρες», δήλωσε ο Δρ. Ο RD Lawrence Fellow, Πανεπιστήμιο του Μπέρμιγχαμ, είπε στο α
δήλωση
στο
Science
Media Centre.
Οι επιστήμονες λένε ότι κατάφεραν να δημιουργήσουν ένα
μίμηση περιβάλλοντος
τις πρώτες 14 ημέρες της ανάπτυξης του εμβρύου εκτός της μήτρας, αν και η εργασία δεν έχει περάσει ακόμη από αξιολόγηση από ομοτίμους.
Τα συνθετικά έμβρυα προκαλούν ανησυχία στην επιστημονική κοινότητα και την κυβέρνηση τόσο στο Ηνωμένο Βασίλειο όσο και στις ΗΠΑ καθώς ανησυχούν για το εάν η ανακάλυψη υπερβαίνει τα όρια της επιστημονικής δεοντολογίας
πολύ μακριά. Αλλά η καθηγήτρια Magdalena Żernicka-Goetz, η οποία είναι η επικεφαλής ερευνήτρια στο έργο, είπε
CNN
ότι τα έμβρυα δεν σχεδιάστηκαν για να δημιουργήσουν νέα ζωή,
αντί μέσα
ελπίδες του
πρόληψη
η απώλεια ζωής.
Τα συνθετικά έμβρυα περιορίζονται επί του παρόντος σε δοκιμαστικούς σωλήνες και δεν μπορούν νόμιμα να εμφυτευθούν στη μήτρα, αλλά οι ερευνητές έχουν
παρόμοια πειράματα σε ποντίκια
και μαϊμούδες.
μι
κάθε φορά όμως που προσπαθούν,
τα συνθετικά έμβρυα δεν έχουν
επέζησε
. Και ενώ το πρόσφατο έργο έχει δημιουργήσει θόρυβο γύρω από τις ευκαιρίες μελέτης της ανθρώπινης ζωής, έχει εγείρει ερωτήματα σχετικά με τον τρόπο ρύθμισης της έρευνας.
Μια σειρά κατευθυντήριων γραμμών βρίσκεται στη διαδικασία θέσπισης από δικηγόρους, ηθικούς και επιστήμονες στο Ηνωμένο Βασίλειο για να «διασφαλιστεί ότι η έρευνα για τα συνθετικά έμβρυα γίνεται με υπευθυνότητα», δήλωσε ο καθηγητής Roger Sturmey, Καθηγητής Αναπαραγωγικής Ιατρικής στην Ιατρική Σχολή του Hull York. στη δήλωση του Science Media Center.
ο
Η ανάπτυξη εξακολουθεί να δείχνει δυνατότητες, σύμφωνα με τον καθηγητή James Briscoe, αναπληρωτή διευθυντή έρευνας στο Ινστιτούτο Francis Crick, σε μια δήλωση. «Θα μπορούσαν να παρέχουν θεμελιώδη εικόνα για κρίσιμα στάδια της ανθρώπινης ανάπτυξης», είπε.
«Αυτά είναι στάδια που ήταν πολύ δύσκολο να μελετηθούν και είναι μια περίοδος που πολλές εγκυμοσύνες αποτυγχάνουν». Πρόσθεσε: «Η νέα γνώση μπορεί να οδηγήσει σε καλύτερη κατανόηση των αιτιών των αποβολών και των μοναδικών πτυχών της ανθρώπινης ανάπτυξης».